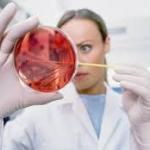
Public Health Laboratories

Labs & Centers
Public Health Laboratories
In 2012, the Faculty of Public Health initiated a large-scale project to upgrade and expand its main teaching laboratories at both the Tripoli and Saida campuses. This achievement transformed the way teaching is offered at the various programs offered by the faculty.

Sciences Laboratories
One of the great benefits of studying Science at Jinan University is the access to advanced laboratory facilities located across the University. With its various thriving departments, including Biology, Biochemistry, and Computer Science, the faculty boasts two impressive laboratory divisions, the Central Laboratory and the Computer Science laboratories.


Language Center
The Language Center is continuing Jinan University’s mission in the realms of knowledge and human cultures.

Translation and Language Laboratories
The Department of Translation and Languages has two language laboratories. These laboratories basically give students the facility of acquiring the basics of listening as one of the most important skills, especially for those who have never learned English as a language of specialization, or other languages that the students would like to learn.

Media Training Center
The Media Center has a central studio which is professionally equipped for filming TV programs using audio-visual equipment.
